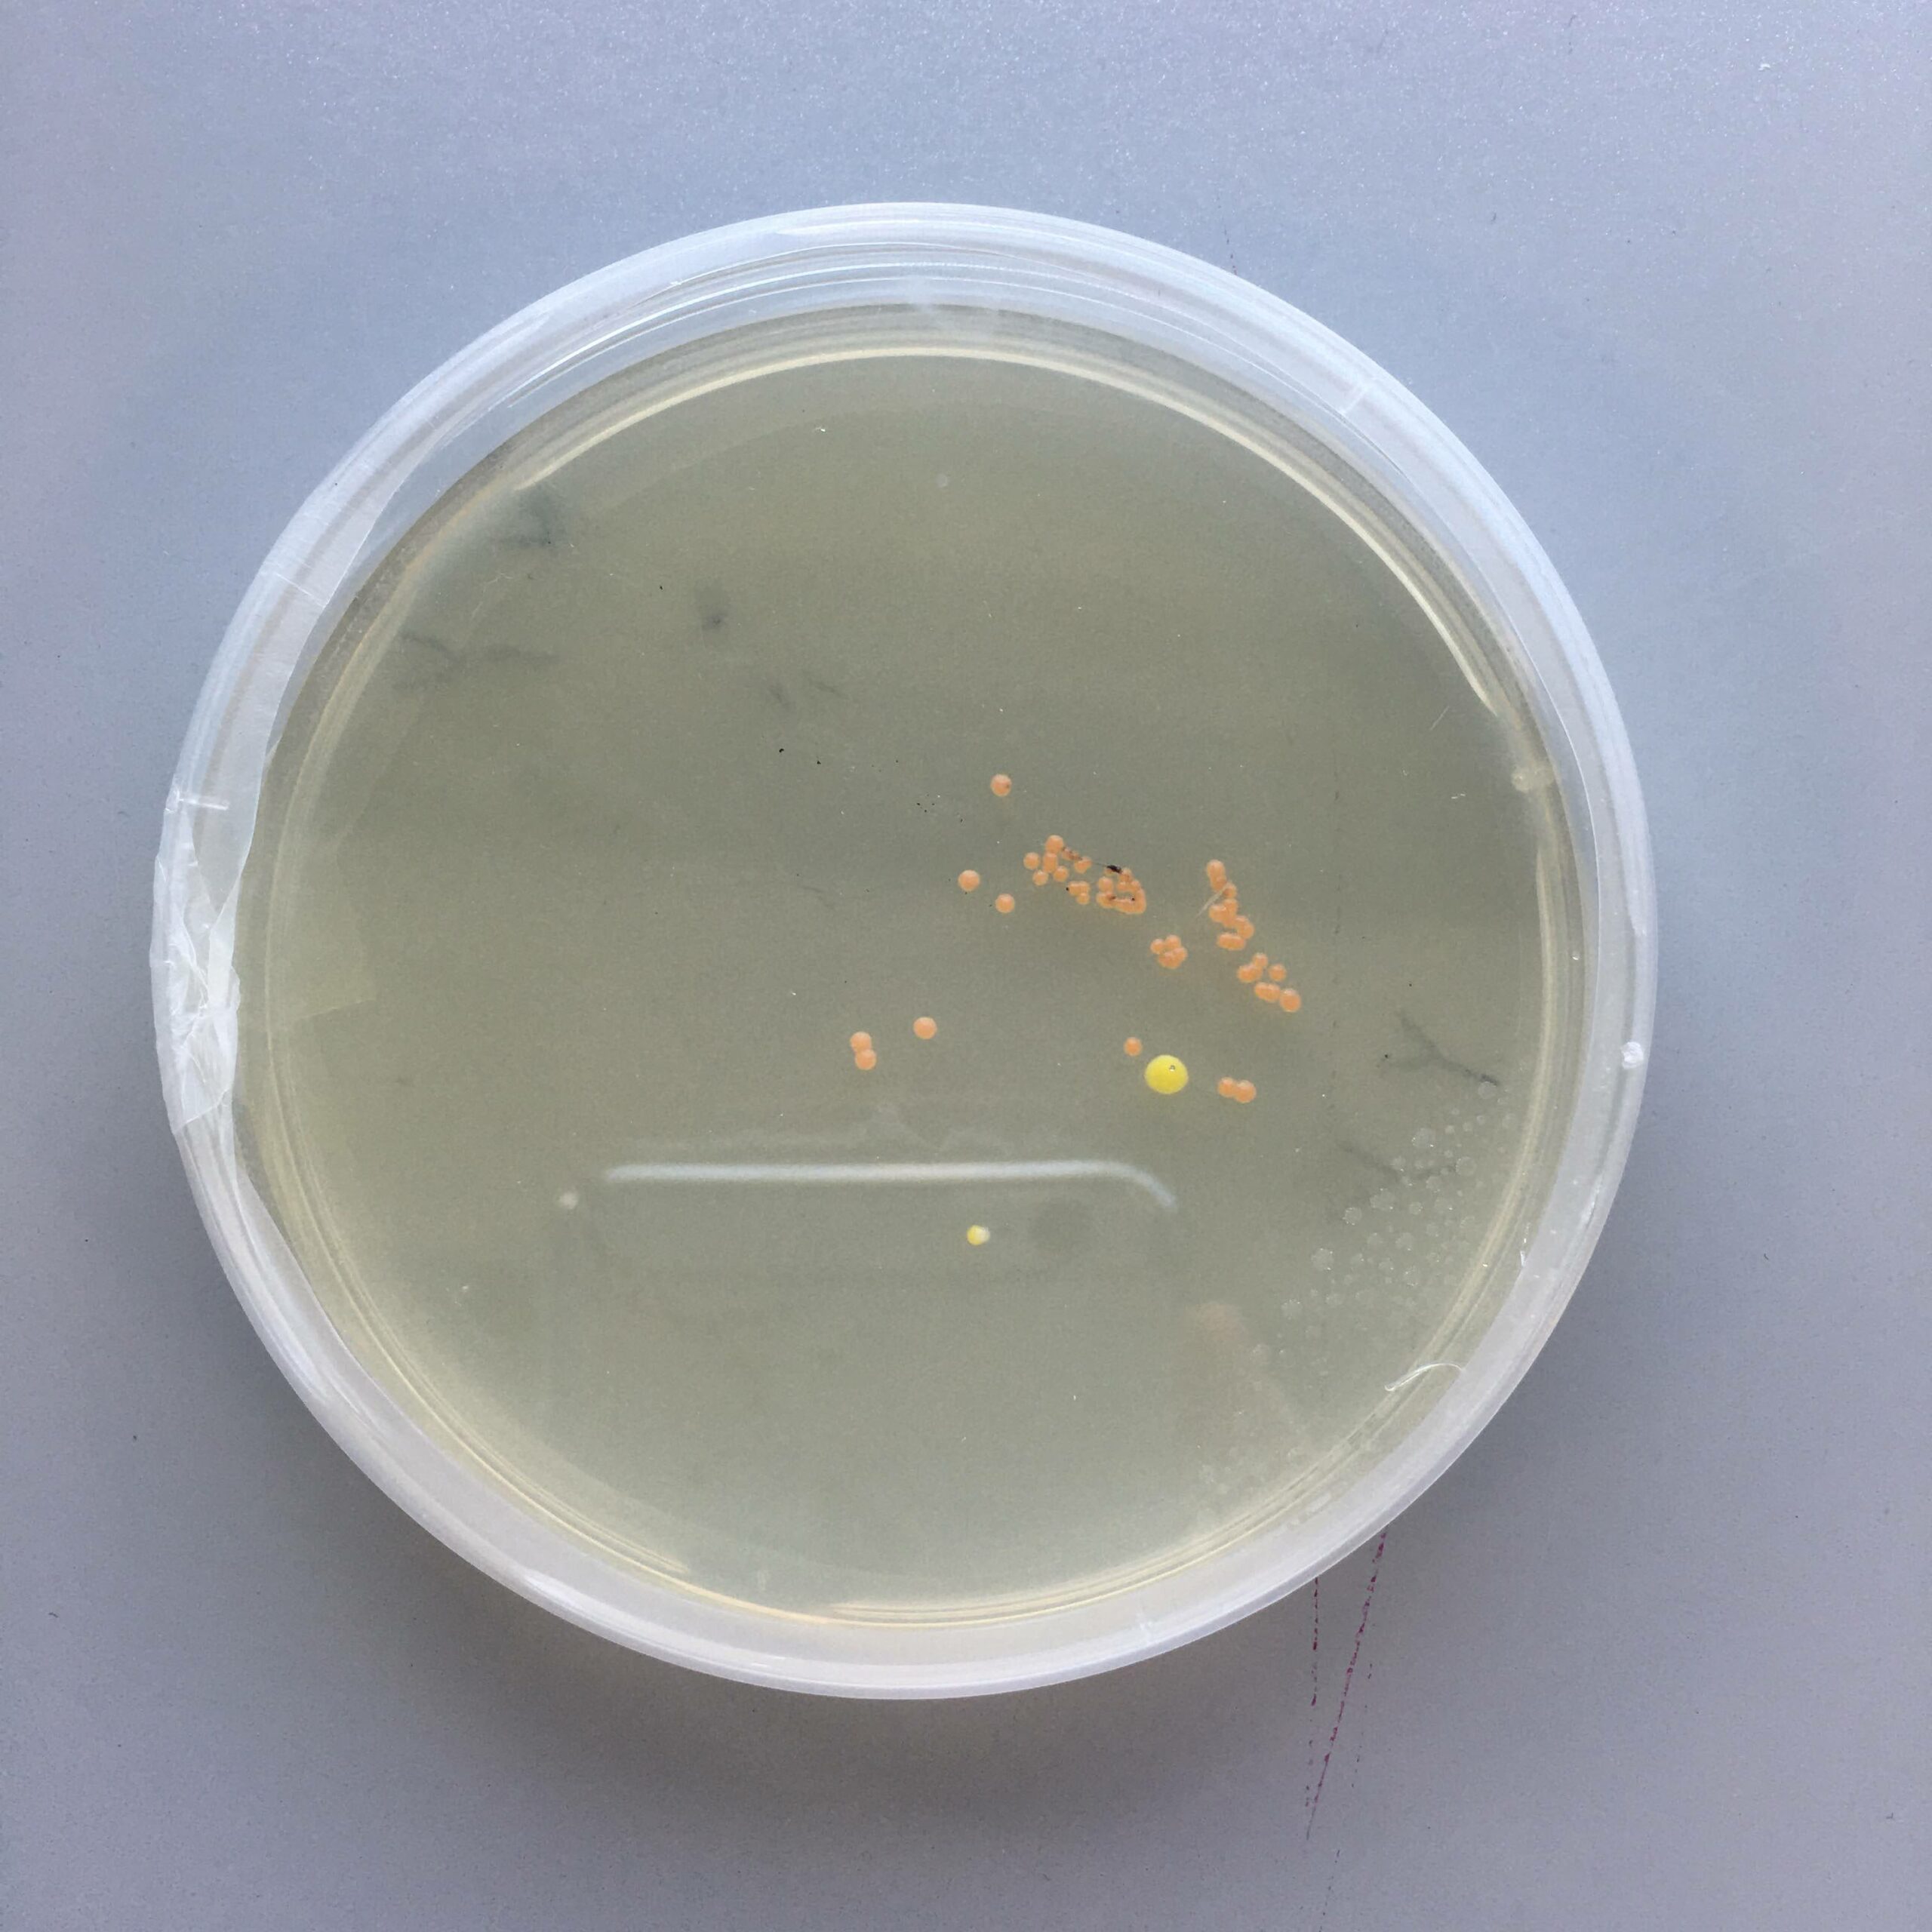

Je hlína, mít doma hlínu! Když jsem ještě bydlela na svém prvním studenstkém bydlení, kde nás bylo na bytě pět, tak jsme moc kytek neměly. Ano ano, neměly s ypsilonem, protože nás bylo pět holek. Takže strašná nuda, navíc poctivky až hanba, včetně mě. Ono taky udržet se v přírodovědném oboru není žádná sranda. Člověk musí mít několik semestrů matematiky, ba co hůř, fyziky, ikdyž se těšil, že po střední už o derivacích a integrálech neuslyší. Tak to je lepší pak být poctivec, jinak biochemie řekne baj báj paní.
Nicméně, radši jsem vždycky zpívala. Tím pádem jsem pro své ne moc valné známky měla vysvětlení, protože jsem přeci dělala umění a už jsem neměla tolik času, jako mají moji spolužáci. Ale opravdu, moje duše umělce opravdu jásala. Japtadaptadá! Tvořili jsme nádhernou hudbu, všichni kolem byli oprsklí přesně tak, jako umělci bývají, a po představení bylo v hospodě další představení. No, to neměl jen tak někdo.

Akorát jsem zestárla a moje hodnoty se proměnily. Zjistila jsem, že spánek je nade vše a alkohol opravdu není potřeba k uvolnění, když je kolem správná společnost. Můj momentální mentální stav je jako na houpačce, ikdyž mám neskutečné štěstí, že o derivacích budu slýchat po celý zbytek svého života a že budu mít po boku úžasného člověka, co mi jejich smysl vždycky vysvětlí.
Obrovské potěšení mi ovšem působí starání se o rostliny. Hlavně o pokojovky a bylinky. Nejenže tvoří kyslík, ale v hlíně žijí bakterie, jejichž kontaminace má vliv na psychický stav člověka. Navíc je to superhipsterský, takže se cítím jako umělec i když už nekouřím dýmku a avo toast si raději udělám doma. Tak si teď tak zpomaluju a snažím se mít v životě hlínu:)



PS: Malý bonus na náladění si
https://www.youtube.com/watch?v=aiVYfxaducs
